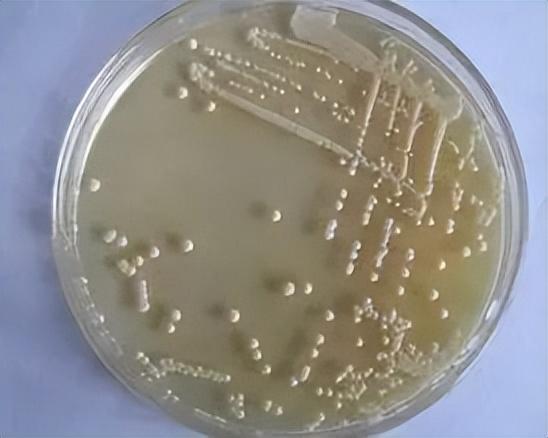
图片

大曲的微生物主要有四类:即霉菌、细菌、酵母菌、放线菌。放线菌为数不多,在大曲中的作用尚不十分明显。
1、霉菌

(1)曲霉属
曲霉是主要的糖化菌,是大曲和其他曲中最多的菌,其时常呈现的颜色有黑、褐、黄、绿、白五色。
曲霉作用于大曲后可形成糖化力、液化力、蛋白质分解力和形成多种有机酸。曲霉中的黑曲霉具有多种活力较强的酶系,糖化力较高,并可产生少量的酒精。曲霉的生长和发酵温度都在35~40℃之间,其习性同根霉。
(2)根霉属
根霉是主要的糖化菌,具有较高的糖化力,且不产转移葡萄糖苷酶,并能产生多种有机酸。根霉分为黑根霉、米根霉、中华根霉、无根根霉几种。大曲中的根霉以米根霉为主,米根霉除具有较强的糖化力外,还兼有一定的发酵力。米根霉的最适生长温度为37~41℃,但它的最适发酵(作用)温度在30~35℃之间。因此,如制曲培菌品温不超过38℃即可达到米根霉大量生长繁殖的目的。所以,目前国内各香型大曲的前期培养品温,一般不超过40℃。
(3)毛霉属
毛霉因其形状似头发状而得名,与根霉极相似,所需的生长发酵温度也差不多。毛霉主要着生于大曲培养的“低温培菌期”,特别是温高湿大,两曲相靠时,更易生长,生产上常常叫做长“水毛”的大多数就是毛霉。在大曲的微生物区分中,属于感染菌,也可以说是有害菌。但毛霉的代谢产物和自身积累的酶系又具有蛋白质分解力,因此少量的毛霉对大曲的“综合能力”可能有一定的作用。
(4)霉菌的作用
霉菌生长代谢能产生多种酶。大曲酒酿造主要利用其代谢产生的液化型、糖化型淀粉酶,作为生产发酵中的糖化剂。
能代谢产生淀粉酶的霉菌有:根霉、曲霉、毛霉等。其中尤以根霉曲霉产生的淀粉酶活力最强,以此为主体的大曲糖化、液化力也较强。大曲生长的霉菌种类和数量受培曲温度的影响。培养温度高,液化能力高,糖化力低;培养温度低,液化力低,糖化力高。
霉菌,特别是毛霉,还能产生一种活性较强的蛋白质分解酶。此酶能催化原料中的蛋白质分子水解为朊、胨、多肽,最后分解形成氨基酸。
2、细菌

有一种说法:糖化动力——霉菌,发酵动力——酵母菌,生香动力——细菌。可见细菌在酿酒中的作用。细菌主要有浓香型白酒中的己酸菌、甲烷菌及丁酸菌;酱香型白酒中的耐高温芽孢杆菌,产乳酸、醋酸、丙酸等有机酸的细菌等。大曲中的细菌主要是球菌和杆菌两种类型,最多的是乳酸菌。
(1)乳酸菌属
大曲中的乳酸菌有三个显著特点:一是既有纯型(同型的),又有异型的;二是球菌居多,占70%;三是所需温度偏低,在28~32℃之间,并具有厌气和好气双重性。大曲中乳酸菌含量不可过多,主要生成区域是在高温转化时由乳酸菌作用于已糖同化生成乳酸,其量的大小往往取决于大曲中乳酸菌的数量和大曲生产发酵对品温的控制。特别是顶点品温不足,热曲时间短时,更会使乳酸大量生成。
乳酸含量的多少是反映曲质的一个方面,由于乳酸所呈现的味是馊、酸、涩等,特别是乳酸在量大时又呈青草味,因此在酿酒上带来的危害就大。一般来说,大曲酒中乳酸及其酯都偏多,所以“增己降乳”应先考虑大曲的“降乳”。
(2)醋酸菌属
醋酸菌的形态各异,但在大曲中以杆菌居多,且是典型的好气性菌。它的作用主要是氧化葡萄糖生成醋酸和少量酒精。它的发酵温度是30℃,偏酸环境。醋酸的功过取决于其含量的大小,在一定量时,它是与醇合成酯的必要成分;当其量大时,不但会使酒味变异,更主要的是它会抑制酵母菌的生长。
醋酸菌主要是在大曲发酵前、中期生长繁殖,尤其是在新曲中含量最多。醋酸菌有一个致命的弱点是干燥低温的环境下芽孢会失去发芽能力。所以,在制备大曲时,要求新曲必须贮存3个月或半年以上,可以使醋酸菌以最少的数量进入酿酒阶段。
(3)枯草芽孢杆菌
枯草芽孢杆菌是大曲中数量最多的细菌之一,它有厌气和好气两种类型,一般最适生长温度为37℃,适应于微酸、湿度大的环境。初期,大曲中芽孢杆菌不多,但其繁殖速度较快,特别是在大曲的高温、高水份、曲块软的区域繁殖较快,此时枯草芽孢杆菌得以大量生长。
(4)细菌的作用
乳酸菌,具有乳酸脱氢酶和乳酸消旋酶,能进行同型和异型乳酸发酵,一般以同型乳酸发酵为主,将葡萄糖经由HDP途径代谢,产生乳酸。
醋酸菌形成的酶具有较强的氧化能力,能利用葡萄糖生产葡萄糖酸,也能氧化乙醇生成乙酸,是发酵酒醅中乙酸的主要产生菌。
芽孢杆菌具有水解淀粉和蛋白质的能力,有的芽胞杆菌能代谢产生酒中的芳香成分双乙酰等。产气芽孢杆菌都有较强的V·P反应(乙酰甲基甲醇反应),与酒中2,3-丁二醇、双乙酰等香味物质的生成有关。
3、酵母菌
(1)酒精酵母
酒精酵母是大曲的主要酵母,其主要特点是生长作用温度低,酒精生成能力强,喜偏酸环境生长,最佳生长温度为28~32℃,pH值在4.5~6.2之间。酵母菌一般在曲坯入房2天(48h)便大量生长繁殖了,其后随着品温的上升而死亡或休眠。酒精酵母与其他酵母相比其数量不算多,但在酿酒上是必不可少的,而且对大曲、大曲酒的产品质量起着决定性的作用。
(2)产酯酵母
产酯酵母能以糖、醛、有机酸、盐类等作为养料,在酯化酶作用下将乙酸与乙醇结合成乙酸乙酯或其他酸酯,所以又把它称为生香酵母。正因为其主要作用是酸醇结合而产生酯,所以该酵母的发酵力不强。其生活习性和所需的生长环境和酒精酵母类似。
(3)假丝酵母属
假丝酵母属包括有产假丝酵母、解酯假丝酵母、热带假丝酵母等。
假丝酵母有很多种都具有酒精发酵能力,它与拟内孢霉共同存在于大曲的表面层,通常呈现为黄色的小斑点。由于其所需温度较低,故主要在“低温培菌期”存活繁殖,当大曲进入高温转化期时,就随其他酵母转入休眠或死亡。
(4)酵母菌的作用
酵母菌在发酵酿酒过程中,具有两个十分突出的作用,即酒化和酯化作用。大曲中的酒精酵母能产生活力较强的酒化酶,能将葡萄糖通过EMP途径代谢转化成酒的主要成分——乙醇,这是曲酒最重要也是最基础的物质。
产酯酵母具有较强的酯合成能力,能代谢产生大量的酯类物质,如己酸乙酯等,能赋予大曲酒浓郁的芬芳。
酵母菌代谢还能产生许多物质,如甘油和其它多元醇等,对酒体的完美与丰满有着重要的作用。